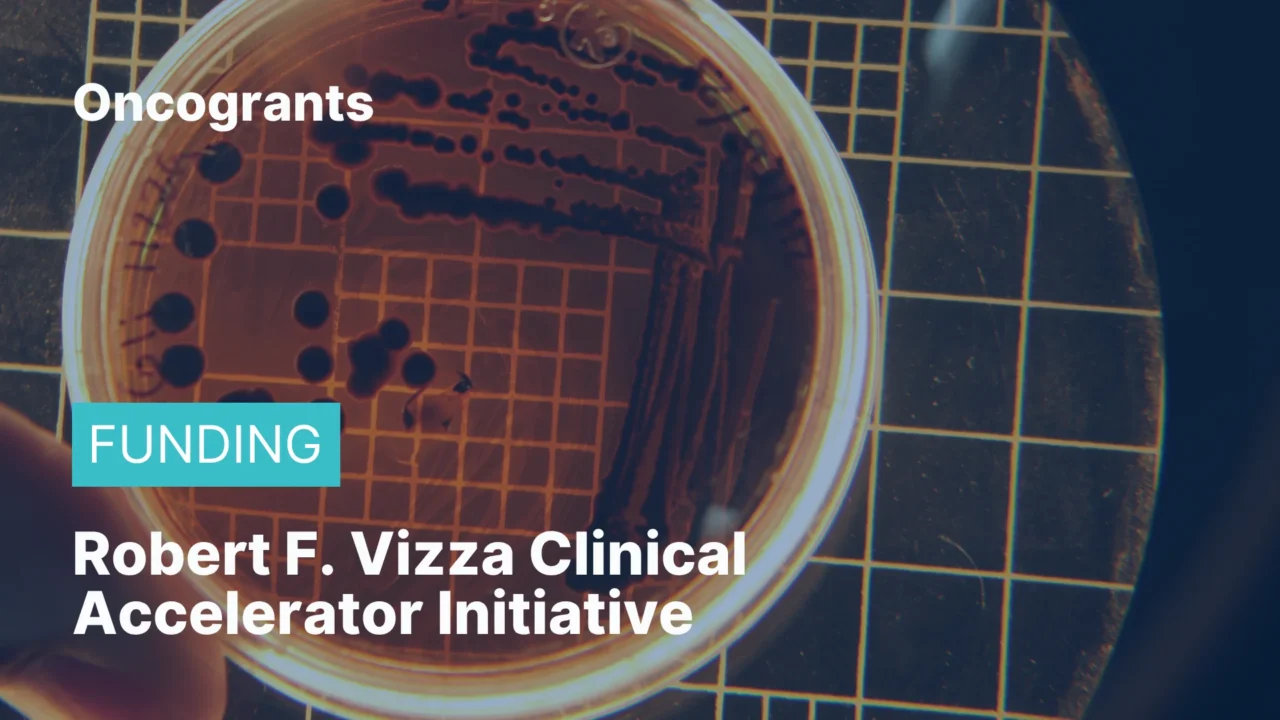
Robert L. Fine Cancer Research Foundation — Research Grant Award

The Robert L. Fine Cancer Research Foundation distributes two awards every other year to outstanding early-career scientists dedicated to basic and translational pancreatic cancer research. The grant supports innovative bench-to-bedside projects that can be carried out in a short period of time with limited resources, including pilot studies, feasibility studies, and development of new methodologies. No LOI required — direct full application submission.
Eligibility Criteria:
Applicants must:
- Hold the rank of Assistant or Associate Professor
- Have been awarded no more than one R01 or R01 equivalent (including competitive renewals)
- Be at a public or private non-profit institution (universities, colleges, hospitals, or laboratories)
- No citizenship requirement; international applicants eligible
- Dual PIs allowable and encouraged for interdisciplinary projects
Funding Details:
- $250,000 in direct costs (no indirect costs covered)
- Duration: 2 years, disbursed in annual installments
- Two awards granted per cycle
- Funding start: January 1, 2027
Deadline:
- Full application due: August 31, 2026, 5:00 PM EST
- No LOI required
Where to go for further information:
- Program details.
- Contact: grants@rlfcrf.org